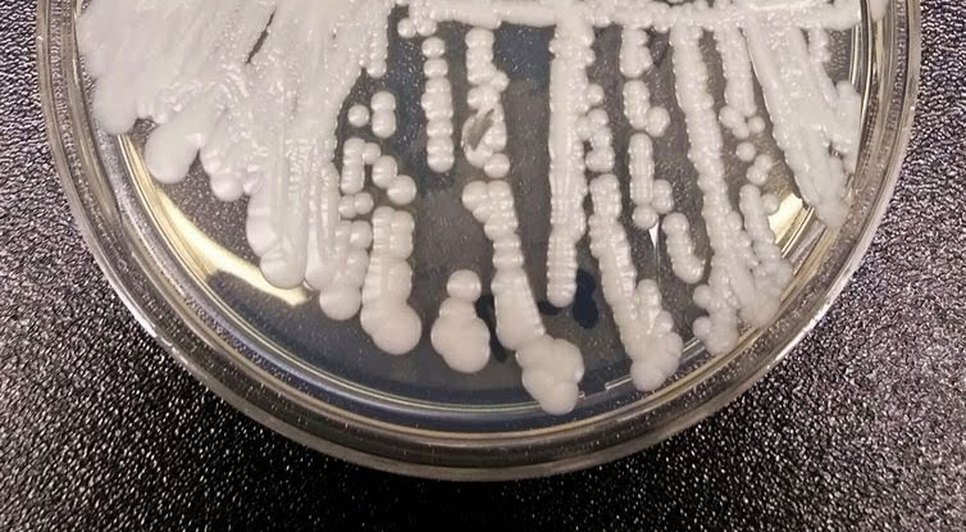

Primeiro caso de superfungo Candida auris é confirmado em São Paulo
Primeiro caso do superfungo Candida auris foi confirmado no estado de São Paulo em um paciente neonatal do Hospital da Mulher Prof. Dr. José Aristodemo Pinotti, da Unicamp (Universidade Estadual de Campinas), na cidade de Campinas.
Segundo as autoridades de saúde, a presença do fungo foi descoberta no dia 18 de maio, após a realização de exames em um paciente que era acompanhado por uma equipe médica e apresentava boa evolução clínica. Seu nome não foi revelado.
Em comunicado, o estado informou que até o momento nenhum outro especialista ou paciente foi diagnosticado com o patógeno e que o departamento continuará implementando novos testes e fortalecendo os procedimentos existentes. “Todas as medidas de contenção da disseminação estão sendo adotadas, com ampla investigação em relação aos profissionais e pacientes do hospital”, informa o comunicado.
Receba notícias em seu WhatsApp
Participe da nossa comunidade